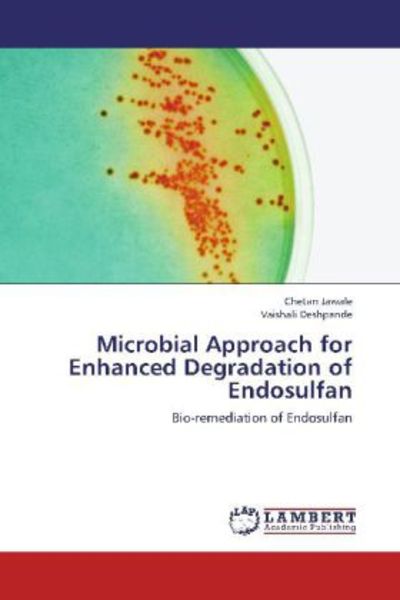

Ergebnisse für "publisher"

Bauen mit Beton für morgen, Taschenbuch von , KIT Scientific Publishing, 9783731514688
€38.00
inkl. MwSt. zzgl. Versand
Versand: €0.00

Die arabischen, persischen und tuerkischen Handschiften der K. K. Orientalischen Akademie - Inktank-Publishing
CHF 17.92
inkl. MwSt. zzgl. Versand

Complete Greek Myths, Gebundene Ausgabe von Anna Milbourne , Henry Brook, Usborne Publishing Ltd, 9781474986441
€33.99
inkl. MwSt. zzgl. Versand
Versand: €0.00

The Unmagical Life of Briar Jones, Taschenbuch von Lex Croucher, Orion Publishing Group, 978-1-399-62464-0
€21.99
inkl. MwSt. zzgl. Versand
Versand: €0.00

Olympia; Die Ergebnisse der von dem Deutschen Reich veranstalteten Ausgrabung - Inktank-Publishing
CHF 17.92
inkl. MwSt. zzgl. Versand

Feruzi, S: Challenges of translating at the interface of Cul, Taschenbuch von Sadiki Moshi Feruzi, LAP LAMBERT Academic Publishing, 9783659107245
€49.00
inkl. MwSt. zzgl. Versand
Versand: €0.00

Der Köhlergraf: Erster Band - Inktank-Publishing
CHF 19.27
inkl. MwSt. zzgl. Versand

Danke Mama - Briefe für alles, was ich dir nie gesagt habe, Taschenbuch von Noemi Weiss, Saya Publishing, 9791388014048
€14.99
inkl. MwSt. zzgl. Versand
Versand: €0.00

Aus der Praxis - Inktank-Publishing
CHF 17.92
inkl. MwSt. zzgl. Versand

Okpalanwankwo, C: Parental engagement, new technologies and, Taschenbuch von Charles Okpalanwankwo, LAP LAMBERT Academic Publishing, 9786200298201
€76.90
inkl. MwSt. zzgl. Versand
Versand: €0.00

The Pact, Taschenbuch von Sharon Bolton, Orion Publishing Group, 978-1-4091-9832-1
€12.99
inkl. MwSt. zzgl. Versand
Versand: €0.00

Kamble, P: Sedentary vs Exercising Subjects, Taschenbuch von Prathamesh Kamble , Barkat Ali Thobani , Mrunal Phatak, LAP LAMBERT Academic Publishing,
€59.00
inkl. MwSt. zzgl. Versand
Versand: €0.00

The Box - Buchbox The Book, Gebundene Ausgabe von , We Mind Publishing GmbH, 9783911408028
€49.00
inkl. MwSt. zzgl. Versand
Versand: €0.00

Der schuldenfreie Staat oder Landwirthschaftliche Ansichten und Erfahrungen E - Inktank-Publishing
CHF 18.52
inkl. MwSt. zzgl. Versand

Ombura! Ombura!, Paperback von Anna Mandus, Palmato Publishing, 978-3-946205-36-4
€16.99
inkl. MwSt. zzgl. Versand
Versand: €0.00

Premium Notizbuch Blank DIN A5: Aimee Stewart, Bücherregal Schatzjäger, Nonbook von Flame Tree Publishing, Browntrout, 978-1-80417-524-8
€16.99
inkl. MwSt. zzgl. Versand
Versand: €2.95

Die Bildnisse der Römischen Kaiser und ihrer Angehörigen, Taschenbuch von Ernst Alfred Stückelberg, LAP LAMBERT Academic Publishing, 9783750316539
€21.00
inkl. MwSt. zzgl. Versand
Versand: €0.00

Mahmood, H: Contribution of FDI in Economic Growth of Pakist, Taschenbuch von Haider Mahmood , A. R. Chaudhary, LAP LAMBERT Academic Publishing,
€49.00
inkl. MwSt. zzgl. Versand
Versand: €0.00

Arshad, S: Vibration Analysis of FGM cylindrical shells, Taschenbuch von Shahid Arshad, LAP LAMBERT Academic Publishing, 9783659153334
€68.00
inkl. MwSt. zzgl. Versand
Versand: €0.00

Der chronische Kopfschmerz und seine Behandlung mit Massage - Inktank-Publishing
CHF 14.51
inkl. MwSt. zzgl. Versand

Herren Grafik T-Shirt Vertrauen Sie mir ich bin ein Verleger – Trust Me I'm A Publisher – Öko-Verantwortlich Vintage Jahrgang Kurzarm Lustige ...
€20.95
inkl. MwSt. zzgl. Versand
Versand: €4.95

Flüchtige Bemerkungen auf einer Reise: im Jahr 1825 - Inktank-Publishing
CHF 19.27
inkl. MwSt. zzgl. Versand

Barannikova, E: Mezhdunarodnye tendery, Taschenbuch von Ekaterina Sergeevna Barannikova, LAP LAMBERT Academic Publishing, 9783659556715
€35.90
inkl. MwSt. zzgl. Versand
Versand: €0.00

Deutsche Volkslieder - Vom Kehrreim des Volksliedes, Taschenbuch von August Wilhelm Grube, LAP LAMBERT Academic Publishing, 9783750314610
€19.50
inkl. MwSt. zzgl. Versand
Versand: €0.00

Paper Piecing Handy Pocket Guide, Taschenbuch von Tacha Bruecher, C & T Publishing, 978-1-61745-967-2
€9.99
inkl. MwSt. zzgl. Versand
Versand: €0.00

Beschreibende Darstellung der aelteren Bau- und Kunstdenkmaeler: des Kreises Grafschaft Hohenstein - Inktank-Publishing
CHF 18.52
inkl. MwSt. zzgl. Versand

Musica sacra : Monatschrift fuer Kirchenmusik - Inktank-Publishing
CHF 17.92
inkl. MwSt. zzgl. Versand

Glücksspielsucht. Was u.a. Dr. Harald Terpe dazu sagt, Taschenbuch von , Dictus Publishing, 9783845468204
€29.00
inkl. MwSt. zzgl. Versand
Versand: €0.00

Waqas, R: Plant Growth Promoting Rhizobacteria:, Taschenbuch von Rashid Waqas , Muhammad Arshad, LAP LAMBERT Academic Publishing, 9783847333975
€49.00
inkl. MwSt. zzgl. Versand
Versand: €0.00

The Broken Afternoon, Taschenbuch von Simon Mason, Quercus Publishing Plc, 9781529446005
€14.00
inkl. MwSt. zzgl. Versand
Versand: €0.00

Grundformen der Orchideen-Arten in Deutschland: und angrenzenden Gebieten - Inktank-Publishing
CHF 19.52
inkl. MwSt. zzgl. Versand

Labyrinth, Taschenbuch von Kate Mosse, Orion Publishing Group, 978-1-4746-2590-6
€19.00
inkl. MwSt. zzgl. Versand
Versand: €0.00

Das Geheimnis der Madame Yin, Paperback von Nathan Winters, BlueCat Publishing GbR, 9783939990345
€14.90
inkl. MwSt. zzgl. Versand
Versand: €0.00

Richard Wagner an Minna Wagner - Inktank-Publishing
CHF 19.92
inkl. MwSt. zzgl. Versand

Back to front. Life is a Story - story.one, Gebundene Ausgabe von Jakub Debowski, Story.one publishing, 9783711503916
€18.00
inkl. MwSt. zzgl. Versand
Versand: €0.00

Geschichte von Pommern: Erster Band - Inktank-Publishing
CHF 19.52
inkl. MwSt. zzgl. Versand

Wind-up Bus, Gebundene Ausgabe von Fiona Watt, Usborne Publishing Ltd, 978-1-4095-6529-1
€25.00
inkl. MwSt. zzgl. Versand
Versand: €0.00

König der Löwen, Lern- und Zaubertafel - Phidal Publishing
CHF 13.95
inkl. MwSt. zzgl. Versand

Alexander Koch's Handbuch neuzeitlicher Wohnungskultur - Inktank-Publishing
CHF 18.52
inkl. MwSt. zzgl. Versand

Green Dot, Taschenbuch von Madeleine Gray, Orion Publishing Group, 978-1-399-61278-4
€13.50
inkl. MwSt. zzgl. Versand
Versand: €0.00

Chourasia, M: Modelling Biomolecules, Taschenbuch von Mukesh Chourasia, LAP LAMBERT Academic Publishing, 9783848401758
€79.00
inkl. MwSt. zzgl. Versand
Versand: €0.00

Mwesige, M: Prostitution And Adultery A Social Cancer, Taschenbuch von Mathius Mwesige, LAP LAMBERT Academic Publishing, 9783848484690
€49.00
inkl. MwSt. zzgl. Versand
Versand: €0.00

Bestimmung der Last-Zeit-Funktion beim Aufprall flüssigkeitsgefüllter Stoßkörper, Taschenbuch von Daniela Ruch, KIT Scientific Publishing,
€68.00
inkl. MwSt. zzgl. Versand
Versand: €0.00

Best of Einfach Backen, Gebundene Ausgabe von , BurdaVerlag Publishing GmbH, 9783000768118
€25.99
inkl. MwSt. zzgl. Versand
Versand: €0.00

Deine fremde Tochter, Taschenbuch von Thomas Fitzner, Dp Digital Publishers, 9783960878476
€14.99
inkl. MwSt. zzgl. Versand
Versand: €0.00

Herren Grafik T-Shirt 100% reiner Superverlag – 100% Pure Super Publisher – Öko-Verantwortlich Vintage Jahrgang Kurzarm Lustige Druck Geburtstag
€20.95
inkl. MwSt. zzgl. Versand
Versand: €4.95

Grundzüge der mathematisch-physikalischen Akustik: 2. Teil - Inktank-Publishing
CHF 19.27
inkl. MwSt. zzgl. Versand

Unternehmerisch investieren, Taschenbuch von Juliane Zielonka, Value Mind Publishing, 9783982423678
€13.99
inkl. MwSt. zzgl. Versand
Versand: €0.00

Siedlung und Verkehr im römischen Reich, Taschenbuch von , Peter Lang Group AG, International Academic Publishers, 9783039100309
€107.00
inkl. MwSt. zzgl. Versand
Versand: €0.00

Sarkar, B: Impact of Welfare Schemes on Disabled Youth in Fa, Taschenbuch von Biplab Sarkar, LAP LAMBERT Academic Publishing, 9783659277290
€49.00
inkl. MwSt. zzgl. Versand
Versand: €0.00

Rosamunda, die Koechin ohne Fehl und Tadel - Inktank-Publishing
CHF 18.52
inkl. MwSt. zzgl. Versand

American Born Chinese, Taschenbuch von Gene Luen Yang, Macmillan Publishers International, 978-1-03-501665-5
€19.00
inkl. MwSt. zzgl. Versand
Versand: €0.00

Geschichte der deutschen Kunst: 1. Teil - Inktank-Publishing
CHF 19.52
inkl. MwSt. zzgl. Versand

Blood of Elves, Taschenbuch von Andrzej Sapkowski, Orion Publishing Group, 978-1-399-61140-4
€13.00
inkl. MwSt. zzgl. Versand
Versand: €0.00

Wesen im Mond Malbuch für Erwachsene, Taschenbuch von Monsoon Publishing,Musterstück Grafik, Epubli, 978-3-7598-6214-3
€10.99
inkl. MwSt. zzgl. Versand
Versand: €0.00

Saha, N: Aspects of HRM for Application of ICTs in the Uni, Taschenbuch von Nimai Chand Saha, LAP LAMBERT Academic Publishing, 9783847331063
€79.00
inkl. MwSt. zzgl. Versand
Versand: €0.00

Stone and Sky, Gebundene Ausgabe von Ben Aaronovitch, Orion Publishing Group, 9781473226715
€25.00
inkl. MwSt. zzgl. Versand
Versand: €0.00

UHV-FTIRS-Untersuchungen an einkristallinen Oxidoberflächen, Taschenbuch von Maria Buchholz, KIT Scientific Publishing, 9783731502005
€49.00
inkl. MwSt. zzgl. Versand
Versand: €0.00

Die Antikörper, Taschenbuch von Emil Freiherr Dungern, LAP LAMBERT Academic Publishing, 9783750315549
€14.00
inkl. MwSt. zzgl. Versand
Versand: €0.00

Skizzenbuch in Worten und Bildern: Aus Westfalen, dem Rheinlande, der Schweiz, Baiern und Sachsen. - Inktank-Publishing
CHF 18.52
inkl. MwSt. zzgl. Versand

HOW TO DEMOTIVATE YOUR EMPLOYEES! Toxische Chefs. Life is a Story - story.one, Gebundene Ausgabe von Elba Carlo, Story.one publishing, 9783710865251
€18.00
inkl. MwSt. zzgl. Versand
Versand: €0.00

Paizo Publishing PZO9315 - Pathfinder Lost Omens: Firebrands | Tabletop
€17.99
inkl. MwSt. zzgl. Versand
Versand: €14.90

Siegfried - Inktank-Publishing
CHF 16.92
inkl. MwSt. zzgl. Versand

Von Freude Frauen sind genannt: Erzählungen - Inktank-Publishing
CHF 18.52
inkl. MwSt. zzgl. Versand

Herren Grafik T-Shirt Es ist eine Verlegersache die Sie nicht verstehen würden – It's A Publisher Thing You Wouldn’t Understand – Öko-Veran...
€20.95
inkl. MwSt. zzgl. Versand
Versand: €4.95

Grand Prix, Gebundene Ausgabe von Will Buxton, Yes Publishing, 978-3-96905-382-9
€32.00
inkl. MwSt. zzgl. Versand
Versand: €0.00

Kaltenborn - Inktank-Publishing
CHF 17.92
inkl. MwSt. zzgl. Versand

Elf Pets Coloring Book for Adults - Monsoon Publishing (Buch)
€11.99
inkl. MwSt. zzgl. Versand
Versand: €0.00

Der Felsen - geliebt - gehasst, Taschenbuch von Helga Capitain, Novum Verlag ein Imprint von novum publishing GmbH, 9783958400979
€13.90
inkl. MwSt. zzgl. Versand
Versand: €0.00

Rebo Publishers Einhorn – Fingerpuppenbuch
€8.99
inkl. MwSt. zzgl. Versand
Versand: €14.99

Angelsaechsisches Lesebuch - Inktank-Publishing
CHF 17.92
inkl. MwSt. zzgl. Versand

Ciné-Passion, Taschenbuch von , Lars Müller Publishers, 978-3-03778-766-3
€25.00
inkl. MwSt. zzgl. Versand
Versand: €0.00

Aus beiden Hemisphären - Inktank-Publishing
CHF 18.52
inkl. MwSt. zzgl. Versand

Evangelische Mission im Nyassa-Lande: Zweite Auflage - Inktank-Publishing
CHF 19.27
inkl. MwSt. zzgl. Versand

Einmischprozesse am Oberrand der konvektiven atmosphärischen Grenzschicht, Taschenbuch von Katja Träumner, KIT Scientific Publishing, 9783866447714
€49.00
inkl. MwSt. zzgl. Versand
Versand: €0.00

Tom Ross Selbstverlag Handbuch E-Publishing 4. Aufl. Taschenbuch englisch
€3.95
inkl. MwSt. zzgl. Versand
Versand: €2.95

Gesundheit und Kunst, Paperback von , New Academia Publishing, 9783700321781
€21.50
inkl. MwSt. zzgl. Versand
Versand: €0.00

Wittenbergs Denkmaler der Bildnerei, Baukunst und Malerei - Inktank-Publishing
CHF 18.52
inkl. MwSt. zzgl. Versand

Licht, Taschenbuch von , Heidelberg University Publishing, 9783946054177
€14.90
inkl. MwSt. zzgl. Versand
Versand: €0.00

Singh, S: Basic Instincts and the World, Taschenbuch von Surinder Singh, LAP LAMBERT Academic Publishing, 9786200286000
€54.90
inkl. MwSt. zzgl. Versand
Versand: €0.00

Brainmaster's Dash und seine furiosen 17. Life is a Story - story.one, Gebundene Ausgabe von Thomas Taschner, Story.one publishing, 9783990878408
€18.00
inkl. MwSt. zzgl. Versand
Versand: €0.00

Die Athembewegungen: Eine physiologisch-pathologische Studie - Inktank-Publishing
CHF 17.92
inkl. MwSt. zzgl. Versand

Verträge zwischen Staat und Kirche im Deutschen Reich - Inktank-Publishing
CHF 19.27
inkl. MwSt. zzgl. Versand

The Cautious Traveller's Guide to The Wastelands, Taschenbuch von Sarah Brooks, Orion Publishing Group, 9781399607551
€13.00
inkl. MwSt. zzgl. Versand
Versand: €0.00
Jawale, C: Microbial Approach for Enhanced Degradation of En, Taschenbuch von Vaishali Deshpande , Chetan Jawale, LAP LAMBERT Academic Publishing,
€59.00
inkl. MwSt. zzgl. Versand
Versand: €0.00

Geistliche Lieder: nebst Biografie - Inktank-Publishing
CHF 17.92
inkl. MwSt. zzgl. Versand

C. S. , V: Design, Architecture And Development of Digital L, Taschenbuch von Venkatarama Reddy C. S., LAP LAMBERT Academic Publishing, 9783847328704
€59.00
inkl. MwSt. zzgl. Versand
Versand: €0.00

Theodor Storm's Briefe in die Heimat aus den Jahren 1853-1864 - Inktank-Publishing
CHF 17.92
inkl. MwSt. zzgl. Versand

Sinha, V: Fundamentals of C++ Programming, Taschenbuch von Vijaay Kumar Sinha , Rubal Jeet , Meenakshi Jaiswal, LAP LAMBERT Academic Publishing,
€82.90
inkl. MwSt. zzgl. Versand
Versand: €0.00

Ein Besuch auf Montenegro - Inktank-Publishing
CHF 18.52
inkl. MwSt. zzgl. Versand

Vergeben, was Man Nicht Vergessen Kann, Taschenbuch von Katharina Weiss, Reichenbacher Publishing GmbH
€16.99
inkl. MwSt. zzgl. Versand
Versand: €0.00

Where Sleeping Girls Lie, Taschenbuch von Faridah Àbíké-Íyímídé, Usborne Publishing Ltd, 9781474967549
€11.50
inkl. MwSt. zzgl. Versand
Versand: €0.00

Premium Notizbuch DIN A5: Garten der Freuden, von Flame Tree Publishing, Flame Tree, 9781804179529
€16.95
inkl. MwSt. zzgl. Versand
Versand: €3.95

Given, Taschenbuch von Elayna R. Gallea, Podium Publishing
€20.99
inkl. MwSt. zzgl. Versand
Versand: €0.00
![Cool Down - Malbuch für Erwachsene: Aachen [Plus Farbvorlage], Taschenbuch von York P. Herpers, Herpers Publishing International, 9783946825593](https://images.thalia.media/00/-/c5c6da561e5748a7a1a7fc3d8d3edbaa/cool-down-malbuch-fuer-erwachsene-aachen-plus-farbvorlage-taschenbuch-york-p-herpers.jpeg)
Cool Down - Malbuch für Erwachsene: Aachen [Plus Farbvorlage], Taschenbuch von York P. Herpers, Herpers Publishing International, 9783946825593
€6.99
inkl. MwSt. zzgl. Versand
Versand: €0.00

WPG-Publisher-Maus zählt bis zehn
€14.49
inkl. MwSt. zzgl. Versand
Versand: €14.99

Die Kunstdenkmäler Badens: Vierter Band - Inktank-Publishing
CHF 19.52
inkl. MwSt. zzgl. Versand

Erzählungen für die gebildete Jugend: Zweiter Band - Inktank-Publishing
CHF 17.92
inkl. MwSt. zzgl. Versand

Optische Antennen aus Al und Au: Anregungskonzepte und Einfluss der Oxidation, Taschenbuch von Patrick Schwab, KIT Scientific Publishing,
€53.00
inkl. MwSt. zzgl. Versand
Versand: €0.00

Sourcery, Gebundene Ausgabe von Terry Pratchett, Orion Publishing Group, 978-1-4732-0016-6
€19.00
inkl. MwSt. zzgl. Versand
Versand: €0.00
